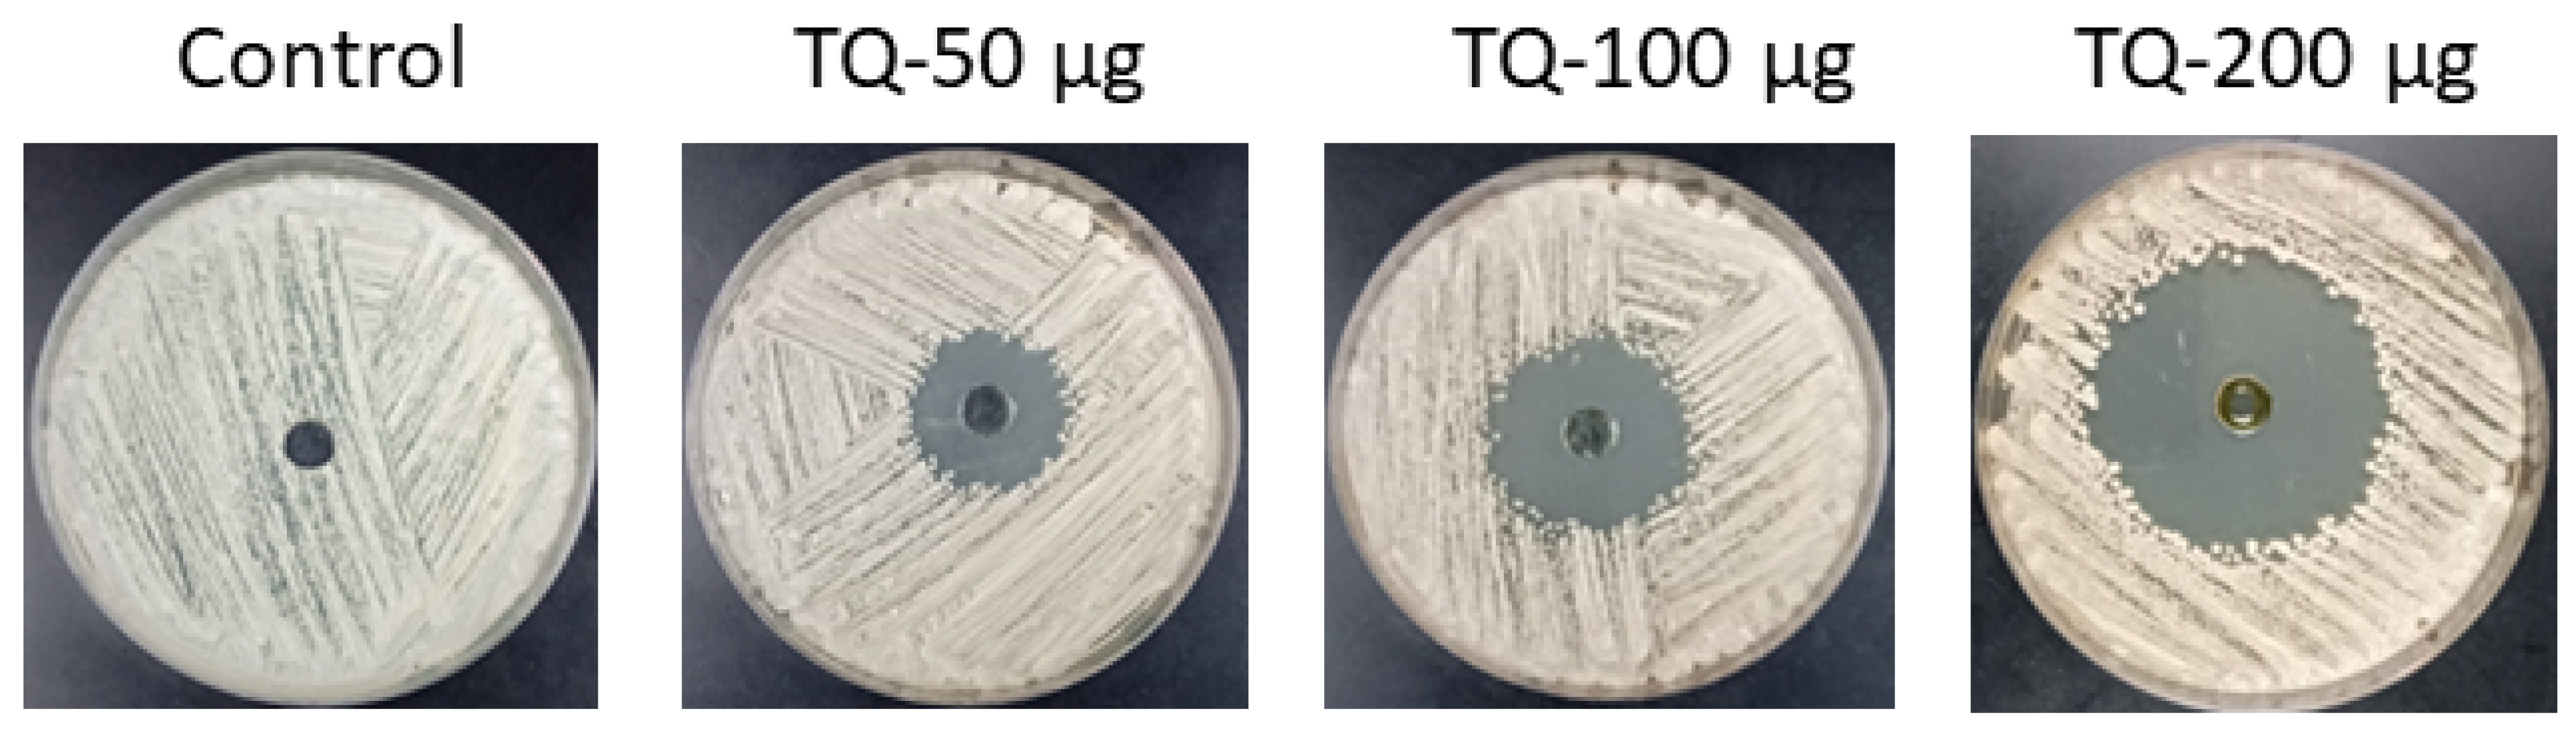
Cimb 46 00771 g005 Cimb 46 00771 g005

In Silico and In Vitro Studies to Explore the Effect of Thymoquinone on Isocitrate Lyase, Biofilm Formation, and the Expression of Some Virulence Genes in Candida albicans
Abstract
1. Introduction
2. Materials and Methods
2.1. Docking Analysis of TQ and Its Interaction with ICL Protein Target
2.2. Simulation Studies Using Molecular Dynamics (MD) to Examine the ICL-TQ Complex
2.3. Candida Albicans
2.4. Effect of TQ on Isocitrate Lyase (ICL) Enzyme Activity of C. albicans
2.5. Determination of Anti-C. albicans Efficiency of TQ
2.6. Time-Kill Assay for Evaluating C. albicans Inhibition Efficiency by TQ
2.7. Inhibitory Effect of TQ on Hyphae Formation
2.8. Inhibitory Effect of C. albicans Biofilm Formation by TQ
2.9. Determination of Virulence Gene Expressions ALS1 and HWP1 by RT-PCR
2.10. Statistical Analysis
3. Results and Discussion
3.1. Binding Interaction Analysis Between ICL and TQ Through Molecular Docking
3.2. MD Simulations
3.2.1. Analysis of Residue Dynamics and Structural Deviations
3.2.2. Evaluating the System’s Stability, Degree of Compactness, and Overall Energy Profile
3.3. Molecular Mechanics Poisson–Boltzmann Surface Area (MMPBSA) Calculations Quantified the Energy Contributions Driving the ICL-TQ Complex Stability
3.4. Thymoquinone Displayed Antifungal Efficacy Against C. albicans
3.5. TQ Demonstrated Significant Inhibition of C. albicans ICL Activity
3.6. TQ Displayed Antifungal Effects in Both In Vitro Assays and Against Intracellular C. albicans
3.7. TQ Suppressed Hyphal Formation in C. albicans, Thereby Decreasing Its Invasive Potential
3.8. TQ Impeded the Proficiency of C. albicans to Form Biofilm
4. Conclusions
Author Contributions
Funding
Institutional Review Board Statement
Informed Consent Statement
Data Availability Statement
Acknowledgments
Conflicts of Interest
References
- Dunn, M.F.; Ramirez-Trujillo, J.A.; Hernández-Lucas, I.; Dunn, M. Major roles of isocitrate lyase and malate synthase in bacterial and fungal pathogenesis. Microbiology 2009, 155, 3166–3175. [Google Scholar] [CrossRef] [PubMed]
- Lee, Y.V.; Wahab, H.A.; Choong, Y.S. Potential inhibitors for isocitrate lyase of Mycobacterium tuberculosis and non-M. tuberculosis: A summary. BioMed Res. Int. 2015, 2015, 8954530. [Google Scholar] [CrossRef]
- Liu, X.; Zang, Y.; Sun, B.; Yin, Y. Optimization of phage heptapeptide library-screening process for developing inhibitors of the isocitrate lyase homologue from Mycobacterium tuberculosis. Med. Chem. Res. 2014, 23, 2543–2553. [Google Scholar] [CrossRef]
- Krátký, M.; Vinová, J.; Novotná, E.; Mandíková, J.; Wsól, V.; Trejtnar, F.; Ulmann, V.; Stolaříková, J.; Fernandes, S.; Bhat, S.; et al. Salicylanilide derivatives block Mycobacterium tuberculosis through inhibition of isocitrate lyase and methionine aminopeptidase. Tuberculosis 2012, 92, 434–439. [Google Scholar] [CrossRef]
- Kozic, J.; Novotná, E.; Volková, M.; Stolaříková, J.; Trejtnar, F.; Wsól, V.; Vinšová, J. Synthesis and in vitro antimycobacterial and isocitrate lyase inhibition properties of novel 2-methoxy-2′-hydroxybenzanilides, their thioxo analogues and benzoxazoles. Eur. J. Med. Chem. 2012, 56, 108–119. [Google Scholar] [CrossRef]
- Shingnapurkar, D.; Dandawate, P.; Anson, C.E.; Powell, A.K.; Afrasiabi, Z.; Sinn, E.; Pandit, S.; Venkateswara, K.S.; Franzblau, S.; Padhye, S. Synthesis and characterization of pyruvate-isoniazid analogs and their copper complexes as potential ICL inhibitors. Bioorg. Med. Chem. Lett. 2012, 22, 3172–3176. [Google Scholar] [CrossRef]
- Sriram, D.; Yogeeswari, P.; Methuku, S.; Vyas, D.R.; Senthilkumar, P.; Alvala, M.; Jeankumar, V.U. Synthesis of various 3-nitropropionamides as Mycobacterium tuberculosis isocitrate lyase inhibitors. Bioorg. Med. Chem. Lett. 2011, 21, 5149–5154. [Google Scholar] [CrossRef]
- Yin, Y.-H.; Niu, X.; Sun, B.; Teng, G.-S.; Zhao, Y.-H.; Wu, C.-M. Screening peptide inhibitors using phage peptide library with isocitrate lyase in Mycobacterium tuberculosis as target. Chem. Res. Chin. Univ. 2011, 27, 635–640. [Google Scholar]
- Bouthenet, E.; Oh, K.-B.; Park, S.; Nagi, N.K.; Lee, H.-S.; Matthews, S.E. Synthesis and antimicrobial activity of brominated resorcinol dimers. Bioorg. Med. Chem. Lett. 2011, 21, 7142–7145. [Google Scholar] [CrossRef]
- Oh, K.-B.; Jeon, H.B.; Han, Y.-R.; Lee, Y.J.; Park, J.; Lee, S.H.; Yang, D.; Kwon, M.; Shin, J.; Lee, H.S. Bromophenols as Candida albicans isocitrate lyase inhibitors. Bioorg. Med. Chem. Lett. 2010, 20, 6644–6648. [Google Scholar] [CrossRef]
- Yang, H.-C.; Yu, J.; Oh, K.-B.; Shin, D.S.; Cho, W.J.; Shin, J.; Kim, S. Synthesis and evaluation of hydroquinone derivatives as inhibitors of isocitrate lyase. Arch. Pharm. Res. 2007, 30, 955–961. [Google Scholar] [CrossRef] [PubMed]
- Kwai, B.X.C.; Collins, A.J.; Middleditch, M.J.; Sperry, J.; Bashiri, G.; Leung, I.K.H. Itaconate is a covalent inhibitor of the Mycobacterium tuberculosis isocitrate lyase. RSC Med. Chem. 2020, 12, 57–61. [Google Scholar] [CrossRef] [PubMed]
- McFadden, B.A.; Purohit, S. Itaconate, an isocitrate lyase directed inhibitor in Pseudomonas indigofera. J. Bacteriol. 1977, 131, 136–144. [Google Scholar] [CrossRef] [PubMed]
- Jung, M.; Kyoung, H.J.; Kim, B.; Lee, B.H.; Choi, B.W.; Oh, K.B.; Shin, J. Meroditerpenoids from the brown alga Sargassum siliquastrum. J. Nat. Prod. 2008, 71, 1714–1719. [Google Scholar] [CrossRef]
- Chang, Y.H.; Shin, D.; Na, Z.; Lee, H.S.; Kim, D.D.; Oh, K.B.; Shin, J. Dihydroxystyrene metabolites from an association of the sponges Poecillastra wondoensis and Jaspis sp. J. Nat. Prod. 2008, 71, 779–783. [Google Scholar] [CrossRef]
- Lee, H.-S.; Yoon, K.-M.; Han, Y.-R.; Lee, K.J.; Chung, S.C.; Kim, T.I.; Lee, S.H.; Shin, J.; Oh, K.B. 5-Hydroxyindole-type alkaloids, as Candida albicans isocitrate lyase inhibitors, from the tropical sponge Hyrtios sp. Bioorg. Med. Chem. Lett. 2009, 19, 1051–1053. [Google Scholar] [CrossRef]
- Bai, B.; Xie, J.-P.; Yan, J.-F.; Wang, H.-H.; Hu, C.-H. A high throughput screening approach to identify isocitrate lyase inhibitors from traditional Chinese medicine sources. Drug Dev. Res. 2006, 67, 818–823. [Google Scholar] [CrossRef]
- Satala, D.; Gonzalez-Gonzalez, M.; Smolarz, M.; Surowiec, M.; Kulig, K.; Wronowska, E.; Zawrotniak, M.; Kozik, A.; Rapala-Kozik, M.; Karkowska-Kuleta, J. The Role of Candida albicans Virulence Factors in the Formation of Multispecies Biofilms With Bacterial Periodontal Pathogens. Front. Cell. Infect. Microbiol. 2022, 11, 765942. [Google Scholar] [CrossRef]
- Inci, M.; Altay, M.A.; Ozer, B.; Evirgen, O.; Duran, N.; Motor, K.V.; Koç, N.A.; Onlen, Y.; Kilinç, C.; Durmaz, S. Investigations of ALS1 and HWP1 genes in clinical isolates of Candida albicans. Turk. J. Med. Sci. 2013, 43, 125–130. [Google Scholar] [CrossRef]
- Roudbarmohammadi, S.; Roudbary, M.; Bakhshi, B.; Katiraee, F.; Mohammadi, R.; Falahati, M. ALS1 and ALS3 gene expression and biofilm formation in Candida albicans isolated from vulvovaginal candidiasis. Adv. Biomed. Res. 2016, 5, 105. [Google Scholar] [CrossRef]
- Younus, H. Molecular and Therapeutic Actions of Thymoquinone; Springer: Berlin/Heidelberg, Germany, 2018; pp. 1–85. [Google Scholar] [CrossRef]
- Khan, M.A. Antimicrobial actions of thymoquinone. In Molecular and Therapeutic Actions of Thymoquinone; Younus, H., Ed.; Springer: Berlin/Heidelberg, Germany, 2018; pp. 57–64. [Google Scholar] [CrossRef]
- Ahmad, Z.; Laughlin, T.F.; Kady, I.O. Thymoquinone inhibits Escherichia coli ATP synthase and cell growth. PLoS ONE 2015, 10, e0127802. [Google Scholar] [CrossRef] [PubMed]
- Khan, M.T.; Ali, A.; Wei, X.; Nadeem, T.; Muhammad, S.; Al-Sehemi, A.G.; Wei, D. Inhibitory effect of thymoquinone from Nigella sativa against SARS-CoV-2 main protease: An in-silico study. Braz. J. Biol. 2022, 84, e250667. [Google Scholar] [CrossRef] [PubMed]
- Tabassum, H.; Ahmad, I.Z. Molecular docking and dynamics simulation analysis of thymoquinone and thymol compounds from Nigella sativa L. that inhibit Cag A and Vac A oncoproteins of Helicobacter pylori: Probable treatment of H. pylori infections. Med. Chem. 2021, 17, 146–157. [Google Scholar] [CrossRef] [PubMed]
- Trott, O.; Olson, A.J. AutoDock Vina: Improving the speed and accuracy of docking with a new scoring function, efficient optimization, and multithreading. J. Comput. Chem. 2010, 31, 455–461. [Google Scholar] [CrossRef] [PubMed]
- Pettersen, E.F.; Goddard, T.D.; Huang, C.C.; Couch, G.S.; Greenblatt, D.M.; Meng, E.C.; Ferrin, T.E. UCSF Chimera—A visualization system for exploratory research and analysis. J. Comput. Chem. 2004, 25, 1605–1612. [Google Scholar] [CrossRef]
- Van Der Spoel, D.; Lindahl, E.; Hess, B.; Groenhof, G.; Mark, A.E.; Berendsen, H.J. GROMACS: Fast, flexible, and free. J. Comput. Chem. 2005, 26, 1701–1718. [Google Scholar] [CrossRef]
- Maier, J.A.; Martinez, C.; Kasavajhala, K.; Wickstrom, L.; Hauser, K.E.; Simmerling, C. ff14SB: Improving the accuracy of protein side chain and backbone parameters from ff99SB. J. Chem. Theory Comput. 2015, 11, 3696–3713. [Google Scholar] [CrossRef]
- Sousa Da Silva, A.W.; Vranken, W.F. ACPYPE—AnteChamber PYthon Parser interfacE. BMC Res. Notes 2012, 5, 367. [Google Scholar] [CrossRef]
- Bussi, G.; Donadio, D.; Parrinello, M. Canonical sampling through velocity rescaling. J. Chem. Phys. 2007, 126, 014101. [Google Scholar] [CrossRef]
- Parrinello, M.; Rahman, A. Polymorphic transitions in single crystals: A new molecular dynamics method. J. Appl. Phys. 1981, 52, 7182–7190. [Google Scholar] [CrossRef]
- Darden, T.; York, D.; Pedersen, L. Particle mesh Ewald: An N·log(N) method for Ewald sums in large systems. J. Chem. Phys. 1993, 98, 10089–10092. [Google Scholar] [CrossRef]
- Essmann, U.; Lalith, P.; Berkowitz, M.L. A smooth particle mesh Ewald method. J. Chem. Phys. 1995, 103, 8577–8593. [Google Scholar] [CrossRef]
- Kumari, R.; Kumar, R.; Lynn, A. g_mmpbsa—A GROMACS tool for high-throughput MM-PBSA calculations. J. Chem. Inf. Model. 2014, 54, 1951–1962. [Google Scholar] [CrossRef] [PubMed]
- Ding, Y.; Zhang, K.; Yin, Y.; Wu, J. D319 induced antifungal effects through ROS-mediated apoptosis and inhibited isocitrate lyase in Candida albicans. Biochim. Biophys. Acta Gen. Subj. 2022, 1866, 130050. [Google Scholar] [CrossRef]
- Khan, S.H.; Younus, H.; Allemailem, K.S.; Almatroudi, A.; Alrumaihi, F.; Alruwetei, A.M.; Alsahli, M.A.; Khan, A.; Khan, M.A. Potential of methylglyoxal-conjugated chitosan nanoparticles in treatment of fluconazole-resistant Candida albicans infection in a murine model. Int. J. Nanomed. 2020, 15, 3681–3693. [Google Scholar] [CrossRef]
- M27-A3; Reference method for broth dilution antifungal susceptibility testing of yeasts. Approved standard-third edition; Clinical and Laboratory Standards Institute: Wayne, PA, USA, 2008; Volume 28, pp. 1–25.
- Khan, M.A.; Khan, A.; Azam, M.; Allemailem, K.S.; Alrumaihi, F.; Almatroudi, A.; Alhumaydhi, F.; Azam, F.; Khan, S.H.; Zofair, S.F.F.; et al. Liposomal ellagic acid alleviates cyclophosphamide-induced toxicity and eliminates systemic Cryptococcus neoformans infection in leukopenic mice. Pharmaceutics 2021, 13, 882. [Google Scholar] [CrossRef]
- Britton, K.L.; Langridge, S.; Baker, P.J.; Weeradechapon, K.; Sedelnikova, S.E.; De Lucas, J.R.; Rice, D.W.; Turner, G. The crystal structure and active site location of isocitrate lyase from the fungus Aspergillus nidulans. Structure 2000, 8, 349–362. [Google Scholar] [CrossRef]
- Arif, A.; Hashmi, M.A.; Salam, S.; Younus, H.; Mahmood, R. Interaction of the insecticide bioallethrin with human hemoglobin: Biophysical, in silico and enzymatic studies. J. Biomol. Struct. Dyn. 2022, 11, 6591–6602. [Google Scholar] [CrossRef]
- Hashmi, M.A.; Malik, A.; Arsalan, A.; Khan, M.A.; Younus, H. Elucidation of kinetic and structural properties of eye lens ζ-crystallin: An in vitro and in silico approach. J. Biomol. Struct. Dyn. 2023, 41, 1178–1192. [Google Scholar] [CrossRef]
- Nabi, F.; Ahmad, O.; Khan, Y.A.; Nabi, A.; Hashmi, M.A.; Abul, Q.F.; Masroor, A.; Hisamuddin, M.; Uversky, V.N.; Khan, R.H. Computational studies on phylogeny and drug designing using molecular simulations for COVID-19. J. Biomol. Struct. Dyn. 2022, 40, 10753–10762. [Google Scholar] [CrossRef] [PubMed]
- Quds, R.; Hashmi, M.A.; Iqbal, Z.; Mahmood, R. Interaction of mancozeb with human hemoglobin: Spectroscopic, molecular docking and molecular dynamic simulation studies. Spectrochim. Acta A Mol. Biomol. Spectrosc. 2022, 280, 121503. [Google Scholar] [CrossRef] [PubMed]
- Khamouli, S.; Belaidi, S.; Bakhouch, M.; Chtita, S.; Hashmi, M.A.; Qais, F.A. QSAR modeling, molecular docking, ADMET prediction and molecular dynamics simulations of some 6-arylquinazolin-4-amine derivatives as DYRK1A inhibitors. J. Mol. Struct. 2022, 1258, 132659. [Google Scholar] [CrossRef]
- Ouassaf, M.; Belaidi, S.; Chtita, S.; Lanez, T.; Qais, F.A.; Hashmi, M.A. Combined molecular docking and dynamics simulations studies of natural compounds as potent inhibitors against SARS-CoV-2 main protease. J. Biomol. Struct. Dyn. 2022, 40, 11264–11273. [Google Scholar] [CrossRef]
- Zia, Q.; Rehman, M.T.; Hashmi, M.A.; Siddiqui, S.; Bin Dukhyil, A.; Ahmed, M.Z.; Jamal, A.; Banawas, S.; Almalki, S.G.; Owais, M.; et al. Effect of Date Palm (Phoenix dactylifera) phytochemicals on Aβ1-40 amyloid formation: An in-silico analysis. Front. Neurosci. 2022, 16, 915122. [Google Scholar] [CrossRef]
- Qais, F.A.; Alomar, S.Y.; Imran, M.A.; Hashmi, M.A. In-silico analysis of phytocompounds of Olea europaea as potential anti-cancer agents to target PKM2 protein. Molecules 2022, 27, 5793. [Google Scholar] [CrossRef]
- Muñoz-Elías, E.J.; McKinney, J.D. Mycobacterium tuberculosis isocitrate lyases 1 and 2 are jointly required for in vivo growth and virulence. Nat. Med. 2005, 11, 638–644. [Google Scholar] [CrossRef]
- Fang, F.C.; Libby, S.J.; Castor, M.E.; Fung, A.M. Isocitrate lyase (AceA) is required for Salmonella persistence, but not for acute lethal infection in mice. Infect. Immun. 2005, 73, 2547–2549. [Google Scholar] [CrossRef]
- Lindsey, T.L.; Hagins, J.M.; Sokol, P.A.; Silo-Suh, L.A. Virulence determinants from a cystic fibrosis isolate of Pseudomonas aeruginosa include isocitrate lyase. Microbiology 2008, 154, 1616–1627. [Google Scholar] [CrossRef]
- Ebel, F.; Schwienbacher, M.; Beyer, J.; Heesemann, J.; Brakhage, A.A.; Brock, M. Analysis of the regulation, expression, and localisation of the isocitrate lyase from Aspergillus fumigatus, a potential target for antifungal drug development. Fungal Genet. Biol. 2006, 43, 476–489. [Google Scholar] [CrossRef]
- Ramírez, M.A.; Lorenz, M.C. Mutations in alternative carbon utilization pathways in Candida albicans attenuate virulence and confer pleiotropic phenotypes. Eukaryot. Cell 2007, 6, 280–290. [Google Scholar] [CrossRef] [PubMed]
- Lorenz, M.C.; Fink, G.R. The glyoxylate cycle is required for fungal virulence. Nature 2001, 412, 83–86. [Google Scholar] [CrossRef] [PubMed]
- Chew, S.Y.; Ho, K.L.; Cheah, Y.K.; Ng, T.S.; Sandai, D.; Brown, A.J.P.; Than, L.T.L. Glyoxylate cycle gene ICL1 is essential for the metabolic flexibility and virulence of Candida glabrata. Sci. Rep. 2019, 9, 2843. [Google Scholar] [CrossRef] [PubMed]
- Hans, S.; Fatima, Z.; Hameed, S. Metabolic fitness of Candida albicans is indispensable for functional drug efflux, ergosterol, and chitin biosynthesis. Curr. Med. Mycol. 2020, 6, 9–14. [Google Scholar] [CrossRef]
- Ishola, O.A.; Ting, S.Y.; Tabana, Y.M.; Ahmed, M.A.; Yunus, M.A.; Mohamed, R.; Lung, L.T.; Sandai, D. The role of isocitrate lyase (ICL1) in the metabolic adaptation of Candida albicans biofilms. Jundishapur J. Microbiol. 2016, 9, e38031. [Google Scholar] [CrossRef]
- d’Ostiani, C.F.; Del Sero, G.; Bacci, A.; Montagnoli, C.; Spreca, A.; Mencacci, A.; Ricciardi-Castagnoli, P.; Romani, L. Dendritic cells discriminate between yeasts and hyphae of the fungus Candida albicans: Implications for initiation of T helper cell immunity in vitro and in vivo. J. Exp. Med. 2000, 191, 1661–1674. [Google Scholar] [CrossRef]
- van der Graaf, C.A.; Netea, M.G.; Verschueren, I.; van der Meer, J.W.; Kullberg, B.J. Differential cytokine production and Toll-like receptor signaling pathways by Candida albicans blastoconidia and hyphae. Infect. Immun. 2005, 73, 7458–7464. [Google Scholar] [CrossRef]
- Murciano, C.; Villamón, E.; O’Connor, J.E.; Gozalbo, D.; Gil, M.L. Killed Candida albicans yeasts and hyphae inhibit gamma interferon release by murine macrophages. Infect. Immun. 2006, 74, 5528–5537. [Google Scholar] [CrossRef]
- Marc, G.; Araniciu, C.; Oniga, S.D.; Vlase, L.; Pîrnău, A.; Duma, M.; Măruțescu, L.; Chifiriuc, M.C.; Oniga, O. New N-(oxazolylmethyl)-thiazolidinedione active against Candida albicans biofilm: Potential Als proteins inhibitors. Molecules 2018, 23, 2522. [Google Scholar] [CrossRef]
- Garcia-Sanchez, S.; Aubert, S.; Iraqui, I.; Janbon, G.; Ghigo, J.M.; d’Enfert, C. Candida albicans biofilms: A developmental state associated with specific and stable gene expression patterns. Eukaryot. Cell 2004, 3, 536–545. [Google Scholar] [CrossRef]
- Green, C.B.; Cheng, G.; Chandra, J.; Mukherjee, P.; Ghannoum, M.A.; Hoyer, L.L. RT-PCR detection of Candida albicans ALS gene expression in the reconstituted human epithelium (RHE) model of oral candidiasis and in model biofilms. Microbiology 2004, 150, 267–275. [Google Scholar] [CrossRef] [PubMed][Green Version]
- Staab, J.F.; Bahn, Y.S.; Tai, C.H.; Cook, P.F.; Sundstrom, P. Expression of transglutaminase substrate activity on Candida albicans germ tubes through a coiled, disulfide-bonded N-terminal domain of Hwp1 requires the C-terminal glycosylphosphatidylinositol modification. J. Biol. Chem. 2004, 279, 40737–40747. [Google Scholar] [CrossRef] [PubMed]
- Nobile, C.J.; Nett, J.E.; Andes, D.R.; Mitchell, A.P. Function of Candida albicans adhesin Hwp1 in biofilm formation. Eukaryot. Cell 2006, 5, 1604–1610. [Google Scholar] [CrossRef] [PubMed]
- Nobile, C.J.; Schneider, H.A.; Nett, J.E.; Sheppard, D.C.; Filler, S.G.; Andes, D.R.; Mitchell, A.P. Complementary adhesin function in C. albicans biofilm formation. Curr. Biol. 2008, 18, 1017–1024. [Google Scholar] [CrossRef]
- Kaur, J.; Nobile, C.J. Antifungal drug-resistance mechanisms in Candida biofilms. Curr. Opin. Microbiol. 2023, 71, 102237. [Google Scholar] [CrossRef]
- Fan, Q.; Yuan, Y.; Jia, H.; Zeng, X.; Wang, Z.; Hu, Z.; Gao, Z.; Yue, T. Antimicrobial and anti-biofilm activity of thymoquinone against Shigella flexneri. Appl. Microbiol. Biotechnol. 2021, 105, 4709–4718. [Google Scholar] [CrossRef]
- Randhawa, M.A.; Gondal, M.A.; Al-Zahrani, A.H.; Rashid, S.G.; Ali, A. Synthesis, morphology and antifungal activity of nano-particulated amphotericin-B, ketoconazole and thymoquinone against Candida albicans yeasts and Candida biofilm. J. Environ. Sci. Health A Tox. Hazard. Subst. Environ. Eng. 2015, 50, 119–124. [Google Scholar] [CrossRef]
- Miao, X.; Liu, H.; Zheng, Y.; Guo, D.; Shi, C.; Xu, Y.; Xia, X. Inhibitory effect of thymoquinone on Listeria monocytogenes ATCC 19115 biofilm formation and virulence attributes critical for human infection. Front. Cell. Infect. Microbiol. 2019, 9, 304. [Google Scholar] [CrossRef]

| Primer | 5′-Sequence-3′ | PCR Product Size (bp) | References |
|---|---|---|---|
| ALS1 | Fwd: 5′-GAC TAG TGA ACC AAC AAA TAC CAG A-3′ Rev: 5′-CCA GAA GAA ACA GCA GGT GA-3′ | 318 | [19] |
| HWP1 | Fwd: 5′-ATG ACT CCA GCT GGT TC-3′ Rev: 5′-TAG ATC AAG AAT GCA GC-3′ | 572 | [19] |
| Actin | Fwd: 5′-CCA GCT TTC TAC GTT TCC-3′ Rev: 5′-CTG TAA CCA CGT TCA GAC-3′ | 200 | [20] |
| ICL-TQ Complex | |
|---|---|
| ΔEvdW | −78.476 ± 1.097 |
| ΔEele | −5.548 ± 0.768 |
| ΔEPSE | 47.554 ± 1.587 |
| ΔESASA | −10.628 ± 0.109 |
| ΔEBE | −47.012 ± 1.222 |
Disclaimer/Publisher’s Note: The statements, opinions and data contained in all publications are solely those of the individual author(s) and contributor(s) and not of MDPI and/or the editor(s). MDPI and/or the editor(s) disclaim responsibility for any injury to people or property resulting from any ideas, methods, instructions or products referred to in the content. |
© 2024 by the authors. Licensee MDPI, Basel, Switzerland. This article is an open access article distributed under the terms and conditions of the Creative Commons Attribution (CC BY) license (https://creativecommons.org/licenses/by/4.0/).
Share and Cite
Khan, M.A.; Azam, M.; Younus, H. In Silico and In Vitro Studies to Explore the Effect of Thymoquinone on Isocitrate Lyase, Biofilm Formation, and the Expression of Some Virulence Genes in Candida albicans. Curr. Issues Mol. Biol. 2024, 46, 12951-12967. https://doi.org/10.3390/cimb46110771
Khan MA, Azam M, Younus H. In Silico and In Vitro Studies to Explore the Effect of Thymoquinone on Isocitrate Lyase, Biofilm Formation, and the Expression of Some Virulence Genes in Candida albicans. Current Issues in Molecular Biology. 2024; 46(11):12951-12967. https://doi.org/10.3390/cimb46110771
Chicago/Turabian StyleKhan, Masood Alam, Mohd Azam, and Hina Younus. 2024. "In Silico and In Vitro Studies to Explore the Effect of Thymoquinone on Isocitrate Lyase, Biofilm Formation, and the Expression of Some Virulence Genes in Candida albicans" Current Issues in Molecular Biology 46, no. 11: 12951-12967. https://doi.org/10.3390/cimb46110771
APA StyleKhan, M. A., Azam, M., & Younus, H. (2024). In Silico and In Vitro Studies to Explore the Effect of Thymoquinone on Isocitrate Lyase, Biofilm Formation, and the Expression of Some Virulence Genes in Candida albicans. Current Issues in Molecular Biology, 46(11), 12951-12967. https://doi.org/10.3390/cimb46110771

